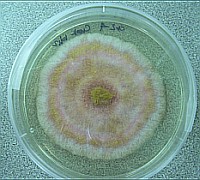
A mosdóban élő gombák veszélyei

A Journal of Clinical Microbiology című szaklapban megjelent tanulmány szerint a fürdőszobák mosdóiban élő fuzáriumgombák igen komoly fertőzéseket okozhatnak.
Az már korábban is ismert volt, hogy a fuzáriumgombák számos kárt okoznak a mezőgazdasági terményekben, azonban egyes fajaik az emberre is veszélyt jelentenek. 2005-2006-ban például az Egyesült Államokban számos kontaktlencsét viselő embert ért utol egy szaruhártya-fertőzés, melynek hátterében szintén ez a gombafaj állt.
A mosdóban élő gombák veszélyei
Forrás: Medipress
A fuzárium által okozott fertőzéseket ráadásul igen nehéz kezelni, mivel ez a faj számos gyógyszerre rezisztens, számoltak be róla a Penn State kutatói, akik közel ötszáz mosdóból vett mintát teszteltek le, melyek a legkülönbözőbb helyekről és államokból származtak. A mosdók hatvanhat, illetve az épületek nyolcvankét százalékában legalább egy féle fuzáriumot találtak, melyek hetven százaléka olyan fajokhoz tartozott, amelyek az emberre is veszélyesek lehetnek.
Dylan Short, a Mezőgazdasági Tudományok Főiskolájának munkatársa úgy vélik, a fenti vizsgálati eredmények alapján egyértelmű, hogy számos ember van kitéve a fuzáriumgombák által okozott fertőzéseknek, mivel a vízvezeték-hálózat felszínén lerakódott biofilm rétegek – azaz egybefüggő réteget képező mikroorganizmusok - kiváló gyűjtőhelyei az emberre veszélyes gombafajnak.
Kövesse az Egészségkalauz cikkeit a Google Hírek-ben, a Facebook-on, az Instagramon vagy a X-en,Tiktok-on is!








